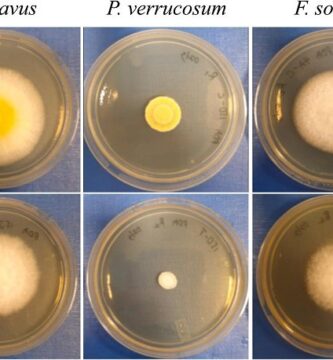

El uso histórico de los hongos en rituales y ceremonias

Hongos en la fabricación de instrumentos musicales

La relación entre los hongos y las abejas en la polinización

Hongos en la biorremediación de suelos contaminados por productos químicos industriales

Hongos en la producción de biopelículas para envasado de alimentos

Hongos en la biorremediación de suelos contaminados por hidrocarburos